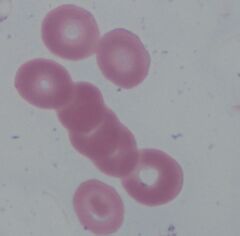
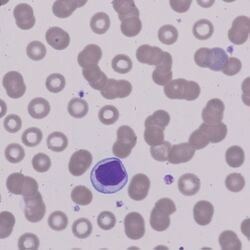
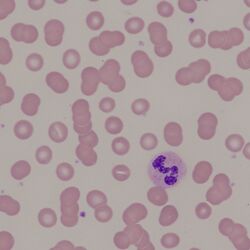

Rouleaux
From haematologyetc.co.uk
Description'
Long or short columns of “stacked” erythrocytes: the cells form a “cup-like” structure so that each successive cell fits into the concave surface of the cell beneath.
Appearances: Rouleaux have a typical form of a single “stack” of erythrocytes forming a line. Since each cell fits into the “cup-shape” of the cell beneath, the rouleaux will not generally branch or clump. Also, since the structure depends on the capability of cells to form a cup shape, damaged cells such as spherocytes, or non-red cells are generally excluded from the structures.
Significance
Rouleaux is a normal finding in the “thick” part of a blood film, but if present in the normal viewing area of the blood film it should be regarded as significant (although not necessarily pathological). Where marked rouleaux is present a cause should be sought: consider physiological causes such as pregnancy, reactive causes such as chronic inflammation, or neoplastic cause due to excess immunoglobulin production (including myeloma and Waldenstrõm's macroglobulinaemia) - in these conditions the high protein levels in serum may give a blue shade to the background of the slide. As a general rule, the more severe the appearance the more significant it is likely to be, additionally it is important to look for confirmatory evidence of increased background protein staining (a blue tinge to the slide background) or signs of cause: circulating abnormal cells.
Pitfalls
Rouleaux is rarely confused with agglutination since the appearance of “stacked cells” and “clumped cells” is very different. The major distinction is whether the rouleaux is significant. Marked rouleux is easy to detect, but determining whether mild forms are significant is inevitably subjective.
1. Causes
Although we tend to associate rouleaux with the high plasma immunoglobulin seen in myeloma or related conditions, in fact physiological causes or inflammation are more common cause of the appearance.
| Physiological |
|---|
| Present in the "thick" area of the blood film |
| Due to the high concentration of fibrinogen seen in pregnancy or post-operatively |
| Raised immunoglobulin (monoclonal) |
| Myeloma
Waldenström’s macroglobulinaemia Other lymphoma (uncommon) |
| Acute phase response (reactive) |
| Chronic inflammatory conditions: e.g. rheumatoid disease, SLE
Chronic infection, particularly endocarditis, TB, HIV |
Clinical Examples
Clinical Image 1: A large number of long red-cell stacks are present. There is also a circulating plasma cell and a blue tinge to the background staining: very significant rouleaux. Clinical condition: Myeloma
Clinical Image 2: Here the red cells still may be single, but the majority lie in groups of 2 or more. This is significant rouleaux. Clinical condition: Myeloma with IgG paraprotein
Pathobiology
Circulating red cells can form cup-like structures, allowing them stack into long columns – a process that is promoted and stabilised by large protein molecules present in plasma. This can be normal where cell number is high and blood flow low – e.g. in the peripheral circulation or on the thick part of blood films. However, excessive rouleaux formation reflects high plasma protein concentration e.g. acute phase protein response to infection or myeloma. The formation of rouleaux in the test tube gives rise to the high ESR seen in conditions where rouleaux occurs since the stacks of cells sediment rapidly.